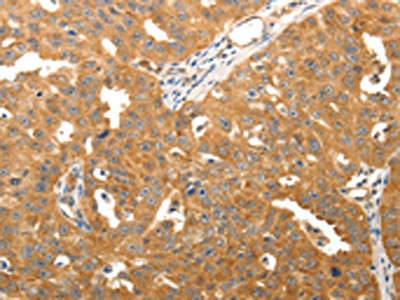

TNN Antibody
-
中文名稱:TNN兔多克隆抗體
-
貨號(hào):CSB-PA681598
-
規(guī)格:¥1100
-
圖片:
-
The image on the left is immunohistochemistry of paraffin-embedded Human liver cancer tissue using CSB-PA681598(TNN Antibody) at dilution 1/50, on the right is treated with synthetic peptide. (Original magnification: ×200)
-
The image on the left is immunohistochemistry of paraffin-embedded Human ovarian cancer tissue using CSB-PA681598(TNN Antibody) at dilution 1/50, on the right is treated with synthetic peptide. (Original magnification: ×200)
-
-
其他:
產(chǎn)品詳情
-
Uniprot No.:
-
基因名:
-
別名:TNN antibody; TNW antibody; Tenascin-N antibody; TN-N antibody; Tenascin-W antibody; TN-W antibody
-
宿主:Rabbit
-
反應(yīng)種屬:Human,Mouse
-
免疫原:Synthetic peptide of Human TNN
-
免疫原種屬:Homo sapiens (Human)
-
標(biāo)記方式:Non-conjugated
-
抗體亞型:IgG
-
純化方式:Antigen affinity purification
-
濃度:It differs from different batches. Please contact us to confirm it.
-
保存緩沖液:-20°C, pH7.4 PBS, 0.05% NaN3, 40% Glycerol
-
產(chǎn)品提供形式:Liquid
-
應(yīng)用范圍:ELISA,IHC
-
推薦稀釋比:
Application Recommended Dilution ELISA 1:3000-1:10000 IHC 1:50-1:200 -
Protocols:
-
儲(chǔ)存條件:Upon receipt, store at -20°C or -80°C. Avoid repeated freeze.
-
貨期:Basically, we can dispatch the products out in 1-3 working days after receiving your orders. Delivery time maybe differs from different purchasing way or location, please kindly consult your local distributors for specific delivery time.
-
用途:For Research Use Only. Not for use in diagnostic or therapeutic procedures.
相關(guān)產(chǎn)品
靶點(diǎn)詳情
-
功能:Extracellular matrix protein that seems to be a ligand for ITGA8:ITGB1, ITGAV:ITGB1 and ITGA4:ITGB1. Involved in neurite outgrowth and cell migration in hippocampal explants. During endochondral bone formation, inhibits proliferation and differentiation of proteoblasts mediated by canonical WNT signaling. In tumors, stimulates angiogenesis by elongation, migration and sprouting of endothelial cells. Expressed in most mammary tumors, may facilitate tumorigenesis by supporting the migratory behavior of breast cancer cells.
-
基因功能參考文獻(xiàn):
- This study demonstrated that the genetic defect was totally or partly clarified in 21 patients with nine of them having potential disease-causing mutations in TTN. PMID: 26627873
- Results show that tenascin-W acts as a niche component for breast cancer metastasis to bone by supporting cell migration and cell proliferation of the cancer cells. PMID: 25868708
- The expression of tenascin-W is dependent on p38MAPK and JNK signaling pathways in mammary tumors. (tenascin-W) PMID: 15592496
- data imply that tenascin-W expression in the activated tumor stroma facilitates tumorigenesis by supporting the migratory behavior of breast cancer cells PMID: 17909022
- results reveal a clear association between elevated levels of tenascin-W and the presence of colorectal cancer and breast cancer PMID: 18306355
顯示更多
收起更多
-
亞細(xì)胞定位:Secreted, extracellular space, extracellular matrix.
-
蛋白家族:Tenascin family
-
組織特異性:Not detected in normal adult mammary tissues or brain but expressed in most breast tumors and brain tumors, such as glioblastomas, astrocytomas and oligodendrogliomas, tested. In brain tumors, detected around the endothelial cell layer of the clood vessel
-
數(shù)據(jù)庫(kù)鏈接:
Most popular with customers
-
-
YWHAB Recombinant Monoclonal Antibody
Applications: ELISA, WB, IHC, IF, FC
Species Reactivity: Human, Mouse, Rat
-
Phospho-YAP1 (S127) Recombinant Monoclonal Antibody
Applications: ELISA, WB, IHC
Species Reactivity: Human
-
-
-
-
-